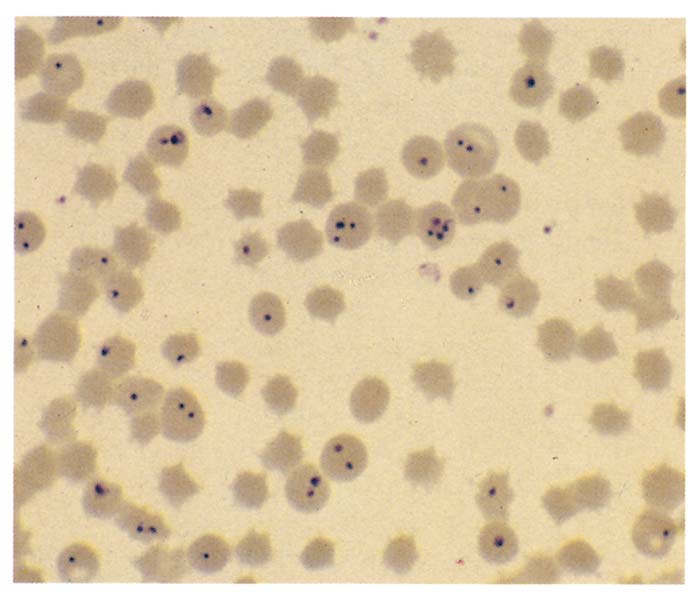

- Infectious Diseases of Livestock
- Part 1
- Equine piroplasmosis
- Vectors: Ticks
- Vectors: Tsetse flies
- Vectors: Muscidae
- Vectors: Tabanidae
- Vectors: Culicoides spp.
- Vectors: Mosquitoes
- Classification, epidemiology and control of arthropod-borne viruses
- Special factors affecting the control of livestock diseases in sub-Saharan Africa
- The control of infectious diseases of livestock: Making appropriate decisions in different epidemiological and socioeconomic conditions
- Infectious diseases of animals in sub-Saharan Africa: The wildlife⁄livestock interface
- Vaccination: An approach to the control of infectious diseases
- African animal trypanosomoses
- Dourine
- Trichomonosis
- Amoebic infections
- GENERAL INTRODUCTION: COCCIDIA
- Coccidiosis
- Cryptosporidiosis
- Toxoplasmosis
- Besnoitiosis
- Sarcocystosis
- Balantidiosis
- Leishmaniosis
- Neosporosis
- Equine protozoal myeloencephalitis
- GENERAL INTRODUCTION: BABESIOSES
- Bovine babesiosis
- Equine piroplasmosis
- Porcine babesiosis
- Ovine babesiosis
- GENERAL INTRODUCTION: THEILERIOSES OF CATTLE
- East Coast fever
- Corridor disease
- Zimbabwe theileriosis
- Turning sickness
- Theileria taurotragi infection
- Theileria mutans infection
- Theileria annulata theileriosis
- Theileriosis of sheep and goats
- Theileria buffeli⁄orientalis infection
- Non-pathogenic Theileria species in cattle
- GENERAL INTRODUCTION: RICKETTSIAL, CHLAMYDIAL AND HAEMOTROPIC MYCOPLASMAL DISEASES
- Heartwater
- Lesser known rickettsial infections in animals and humans
- Chlamydiosis
- Q fever
- Eperythrozoonosis
- Bovine Haemobartonellosis
- Potomac horse fever
- GENERAL INTRODUCTION: ANAPLASMOSES
- Bovine anaplasmosis
- Ovine and caprine anaplasmosis
Equine piroplasmosis
This content is distributed under the following licence: Attribution-NonCommercial CC BY-NC
View Creative Commons Licence details here

Equine piroplasmosis
Previous Authors: D T DE WAAL AND J VAN HEERDEN
Current Authors:
R V BHOORA - Senior Researcher, PhD, Agricultural Research Council, Onderstepoort Veterinary Research, 100 Old Soutpan Road, Onderstepoort, Pretoria, Gauteng, 0110, South Africa
N E COLLINS - Senior Researcher, BSc, MSc, PhD, Faculty of Veterinary Science, Department of Veterinary Tropical Diseases, University of Pretoria, Private Bag X04, Gauteng, 0110, South Africa
Introduction
Equine piroplasmosis (EP) is caused by the intra-erythrocytic, tick-transmitted protozoan parasites Theileria equi120 and Babesia caballi ,131 which generally affect horses, mules, donkeys and zebras. These parasites have also been detected in dogs14, 31 and, more recently, in camels,142, 165 although the epidemiological significance of these detections still needs further investigation. Transmission of equine piroplasmosis can occur either biologically, by ticks of the family Ixodidae, or mechanically, through blood transfusions. This globally significant disease is endemic in most parts of the world and is maintained in equid populations where competent tick vectors are present.161 Both parasites cause disease in equids, which may be either acute or chronic, with mortalities ranging from 5 per cent among horses native to endemic regions, up to and above 50 per cent in naïve horses introduced into endemic regions.150 Infections with either Theileria equi or Babesia caballi result in the lysis of erythrocytes causing varying degrees of haemolytic anemia. Clinical signs are often non-specific and cannot be used to distinguish between Theileria equi and Babesia caballi infections, thus further complicating the diagnosis. Animals that recover often remain persistently infected carriers that act as reservoirs for the spread of these protozoal pathogens by competent tick vectors.
Piroplasmosis in horses was first reported in South Africa around the turn of the 19th century when it was initially described as ‘anthrax fever’,68, 170 ‘biliary fever’,82 ‘a bilous form of African horsesickness’130 and in West Africa as ‘equine malaria’.68 The first detailed study of equine piroplasmosis was the topic of Sir Arnold Theiler’s doctoral dissertation.170 At the beginning of the 20th century, Laveran (1901)103 recognized that the disease was caused by an intraerythrocytic protozoan parasite, which he named Piroplasma equi. A few years later, it was discovered that two morphologically distinct parasites could be identified in horses suffering from what was then known as biliary fever, and the name Piroplasma caballi was given to the larger parasite.97 The parasites were later renamed Babesia caballi131 and Babesia equi.103
All cases of equine piroplasmosis are reportable to the World Organisation for Animal Health (OIE: Office International des Épizooties) as it is considered to be a disease of international importance that negatively affects the movement of horses for trade and participation in equestrian sporting events. While certain countries impose stringent import restrictions to prevent the introduction of these parasites into non-endemic areas, endemic countries limit the entrance of infected horses to prevent the introduction of diverse and potentially more virulent strains.161
Aetiology and life cycle
Babesia and Theileria belong to the phylum Apicomplexa and, in reference to intraerythrocytic forms that are pear-shaped in some species, they form a group called the piroplasms.104 The two piroplasm genera are usually distinguished by the lack of a pre-erythrocytic cycle in Babesia and the lack of transovarial transmission in Theileria. The taxonomy of Theileria equi has remained controversial since its initial discovery in 1901.88, 103, 120 The discovery of exoerythrocytic schizogony in Babesia equi;125, 156 division into four merozoites (“maltese-cross”) in erythrocytes;51 the observation of transstadial transmission by ticks;58 and resistance to certain babesicidal drugs,,23 all led to the reclassification of this parasite as belonging to the genus Theileria .126 This reclassification may be superseded in future, because phylogenetic analysis of the small-subunit ribosomal RNA gene suggested that Theileria equi belongs to a paraphyletic group distinct from both the Theileira and Babesia genera.7 The recent acquisition and analysis of the complete genome sequence of the T. equi USDA Florida strain supports the placement of Theileria equi as a sister lineage to other Theileira spp.88 Further data are required, however, before the taxonomic reclassification of this parasite can be finalized, and therefore, for the purposes of this chapter, the parasite will be referred to as Theileria equi.
The piroplasms have complex life cycles that involve morphologically distinct developmental stages that include an asexual haploid stage in the mammalian host and a diploid sexual stage that occurs in the tick vector.161 A typical apicomplexan life cycle is characterized by three stages of reproduction: (a) gamogony, which is the formation and fusion of gametes inside the tick gut, (b) sporogony, asexual reproduction in the salivary glands and (c) merogony, asexual reproduction in the vertebrate host.104
Theileria equi life cycle
Theileria equi is present in the lymphocytes and erythrocytes of vertebrate hosts and is transmitted exclusively by the bite of vector ticks. Transmission occurs only through the bites of nymphs and adults, as larvae are not pre-infected because transovarial transmission does not occur. Schizogony occurs in the vertebrate host, while gamogony and sporogony take place in ticks.120 The vertebrate host acquires the parasitic infection when sporozoites from infected nymphal or adult ticks are transferred during feeding. Sporozoites initially invade the peripheral blood mononuclear cells (PBMCs) and recent in vitro studies have shown that T and B lymphocytes, macrophages and monocytes become infected,143 Sporozoites undergo schizogony in PBMCs, during which macroschizonts and microschizonts develop, which give rise to merozoites. Theileria equi merozoites are relatively small (2-3 µm long) and are round, amoeboid or piriform.104 Infected PBMCs rupture and the merozoites infect erythrocytes, where they start reproducing by binary fission, frequently resulting in the formation of four pear-shaped parasites in an arrangement referred to as a tetrad or maltese cross. Parasitaemias commonly range between 1 and 5 per cent but up to 80 per cent of erythrocytes may be infected in some cases.59, 125 Infected erythrocytes rupture and erythrocytic merozoites that enter the circulation again infect other erythrocytes, where another phase of asexual reproduction is initiated. Ticks become infected by ingesting infected erythrocytes (gamonts) and the process of gametogenesis is initiated in the tick. Gametocytes undergo morphological changes within the tick’s gut where they develop into ray bodies. Zygotes, formed by the fusion of two ray bodies (gametes), then develop into kinetes that initiate the process of sporogony when they invade the salivary glands. The sporonts persist unchanged in the salivary glands during the nymphal to adult moult. The maturation of sporozoites occurs once an infected adult tick attaches to a vertebrate host.120
Babesia caballi life cycle
The life cycle of Babesia caballi is very similar to that of Theileria equi, but in contrast to Theileria equi, Babesia caballi parasites only go through three stages of development, comprising merogony, gamogony and sporogony. Babesia caballi develops in the vertebrate host exclusively in erythrocytes.57, 76 Infectious sporozoites are transmitted through the tick saliva to the equid host, where they immediately invade erythrocytes. Within the erythrocytes, they multiply and develop into trophozoites and then into merozoites. The merozoites are pear-shaped (pyriform), pointed at their posterior ends, vary in size by between 2 and 5 μm in length and between 1 and 1,5 μm in width, and often form pairs. The angle between these pairs is usually acute.70 The trophozoites are polymorphic, but round, oval or elliptical forms varying between 1,5 and 3 μm in diameter predominate (Figure 2).56 The fine structure of the trophozoites and merozoites is essentially similar to those of other large Babesia spp.70, 164 Red blood cells rarely contain more than two parasites in Babesia caballi infections, unlike the situation in Theileria equi infections. The parasitaemia in the case of Babesia caballi infections is invariably low — usually less than 0,1 per centof erythrocytes are infected even in splenectomized horses.34
When merozoites are ingested by uninfected ticks, the Babesia caballi piroplasms undergo gametogenesis within the epithelial cells of the tick midgut. Successive cycles of schizogony occur and a variety of cell types, including ova, become infected, leading to transovarial transmission. Babesia caballi ookinetes (vermicules) enter the salivary glands at about the time of larval moult (6 to 10 days after attachment) and develop to become sporozoites (the infective forms) shortly after nymphal ticks begin feeding. These sporozoites are liberated into the lumen of the salivary gland and are oval or pyriform bodies, 2,5 to 3 μm long. They are thought to be injected while the nymphs are feeding.73
Epidemiology
Geographically, both Theileria equi and Babesia caballi are distributed throughout the tropical and subtropical regions of the world, where competent tick vectors are present. The rates of infection of equines in endemic areas range from 60 to 90 per cent.23, 60, 161 The international movement of clinically healthy animals into non-endemic regions where competent tick vectors occur forms the basis for the spread of this disease globally. Although the OIE reports that most equid-inhabited regions of the world are considered endemic, there are some countries that do not report all cases of infected horses to the OIE and thus the current status of reporting remains unclear. Endemic areas include many parts of Africa, Europe, the Middle East, and Asia.23, 60 Currently, countries that are considered free of equine piroplasmosis include Australia, Canada, Great Britain, Japan, Ireland and New Zealand.
An outbreak of Theileria equi on a ranch in Southern Texas in 2009 and the identification of two previously unrecognized competent tick vectors (Amblyomma cajennense and Dermacentor variabilis) on many of the horses suggested endemic tick-borne transmission.159, 160 This placed the piroplasm-free status of the United States under scrutiny162 until the establishment of an experimental treatment regimen involving the use of imidocarb dipropionate, which led to the elimination of Theileria equi and thus the risk of transmission.176
Both parasite species occur in Portugal, Spain, France, Switzerland, Greece and Italy.12, 27, 63, 99, 112, 163 Piroplasmosis is also endemic in Hungary, Romania and several countries of the Commonwealth of Independent States and the states of the Caucasus region.50, 59, 79, 187 The introduction of Theileria equi into Australia in the 1950s, 1960s and 1970s, when Spanish horses were imported into the country, was attributed to iatrogenic transmission through the use of contaminated needles.23, 60, 117, 118 Despite the presence of Rhipicephalus (Boophilus) microplus in many parts of the country, the disease never became established and Australia remains piroplasmosis-free.
Equine piroplasmosis is indigenous to many parts of Asia, including Mongolia, China and many parts of Southeast Asia.20, 182, 189 Sporadic reports of Theileria equi and Babesia caballi seropositive horses have also been reported in Japan, despite the country being considered free of infection.84 High seroprevalences of Theileria equi infections have been reported in horses in the Middle East, Jordan, and India.1, 2, 141
Theileria equi and Babesia caballi occur in all regions of South America. Almost all horses in Brazil, Mexico, Colombo and Puerto Rico are seropositive for both parasites.28, 69, 169 No incidences of equine piroplasmosis have, however, been reported in the southern parts of Chile and Argentina. The disease has also been described in the Caribbean islands of Trinidad and Cuba.61, 155
South Africa and many other parts of the African continent are also considered endemic for equine piroplasmosis.16, 41, 147, 154 The disease is widely distributed amongst both horses and zebras in South Africa and coincides with the distribution of the respective tick vectors, Rhipicephalus evertsi evertsi and Hyalomma truncatum.15, 16, 33, 35 Most clinical cases of equine piroplasmosis reported in South Africa are due to Theileria equi infections. (see Vectors: Ticks).
As many as 33 species of ixodid ticks belonging to six genera (Amblyomma, Dermacentor, Haemaphysalis, Hyalomma, Ixodes and Rhipicephalus) have been implicated in the transmission of either Theileria equi or Babesia caballi or both parasites.161 Modes of transmission vary for both parasites due to the differences in their life-cycles and transmission events that differ in different tick species. Theileria equi is generally transmitted either transstadially or intrastadially160, 178 and therefore equids are the only known reservoir of the parasites. In contrast, both infected horses and ticks serve as reservoirs for B. caballi infections as transmission occurs both transstadially and transovarially by its vectors.33, 35 Both parasites are also efficiently iatrogenically transmitted via infected blood transfusions to naïve horses, blood doping or the use of contaminated equipment.23, 59, 162
Intrauterine infections of unborn foals are a common cause of equine abortions. Infection of foals in utero may result in abortion with the foetus showing lesions characteristic of equine piroplasmosis, or in the birth of foals showing signs of the disease.6, 30, 61, 136, 139 Placental damage or the occurrence of reverse erythroblastosis foetalis has been implicated as the cause of transplacental transmission.45, 49 However, a DNA probing assay carried out on six naturally born foals suggested that parasite transmission also occurs in pregnancies where placentation is normal.6 Theileria equi has been reported to be responsible for 11 per cent of abortions in Thoroughbred mares in South Africa.106 However, a recent investigation of the Theileria equi outbreak in Texas identified infected pregnant mares, with no reports of abortions or associated complications.188 Infected foals may be born alive, showing signs of the disease, or they may develop signs within a few days. Due to the persistent nature of the infection, a carrier mare can produce more than one infected foetus, which occurs at random in her life-time. In a recent study it was shown that foetuses can be infected with Theileria equi without their developing disease and that they can be born as carriers of the parasite.105
Foals born in endemic areas usually receive maternal antibodies in the colostrum against Theileria equi and Babesia caballi. Colostral antibodies can be detected for up to five months of age in foals.37, 443 As in the case of calves, foals are protected from Babesia infections by passively acquired and non-specific factors during the first six to nine months of life.37, 44, 58 Infection occurring during this time will cause immunity without any overt signs of disease developing, and an endemically stable situation will develop.37, 58 On the other hand, an endemically unstable disease situation develops when, due to infrequent exposure, some animals fail to become infected for a considerable period (probably more than 12 months) after birth and are then fully susceptible.37 For more information on endemic stability and instability, see Bovine babesiosis.
Following successful transmission, clinical signs are observed within 10 to 30 days for Babesia caballi and 12 to 19 days for Theileria equi.36 The parasitaemia in horses naturally infected with Theileria equi commonly ranges from 1 to 7 per cent but rarely exceeds 1 per cent in Babesia caballi infections.36, 59 After being infected with Babesia caballi, animals may remain carriers of the parasite for up to four years, while the carrier state and immunity is probably life-long after infection by Theileria equi.34, 58 Carrier horses, donkeys, mules and zebras are infective for ticks. Babesia caballi parasites may persist in tick vectors for several generations in the absence of reinfection from an infected equid, and consequently the tick populations can be reservoirs of infection.47, 161 There is no cross-immunity between Theileria equi and Babesia caballi and a horse can be simultaneously infected with both parasites.20, 120
Pathogenesis
Although the pathogenesis of Theileria equi and Babesia caballi infections in horses is not completely understood, these parasites evoke the same pathophysiological events as described for the other Babesia spp. (see Bovine babesiosis). This may well explain the diverse clinical manifestations of disease.
Haemolysis occurs as a result of the physical rupture of erythrocytes when merozoites are released, as well as from the removal of infected erythrocytes from circulation by the spleen. The lysis of erythrocytes results in the development of varying degrees of haemolytic anaemia, which is typical of disease caused by Theileria equi infections.75 The biochemical structure of the erythrocyte membranes also changes dramatically during infection with Theileria equi and this conformational change results in increased rigidity of the erythrocytes and decreased deformability, thus reducing the microvascular blood flow.8
Disseminated intravascular coagulopathy may develop in cases of equine piroplasmosis complicated by other infections, such as African horse sickness or worm infestations. In vitro studies have indicated disturbances in the clotting mechanism but uncomplicated piroplasmosis in horses has not been associated with disseminated intravascular coagulopathy.179
The pathogenesis of the disease in horses infected with Babesia caballi has been related to the formation of microthrombi within small vessels, leading to venous stasis and vasculitis.5, 8, 33, 72 Severe piroplasmosis can result in systemic inflammatory response syndrome, which causes endothelial damage, increased vascular permeability and disseminated intravascular coagulation and subsequent multiorgan failure.42 It is possible that the development of an acute hypotensive state may be the cause of peracute deaths.
The development in some cases of laminitis with gastrointestinal stasis may well be due to the absorption of endotoxins.101, 180 Equids with intact spleens are able to control Theileria equi and Babesia caballi infections; however, splenectomized animals develop high levels of parasitaemia and eventually succumb to the infection.
Clinical signs
Most clinical cases of equine piroplasmosis in southern Africa are caused by Theilera equi. Babesia caballi infection is usually not clinically apparent and is only rarely responsible for severe anaemia and other signs typical of piroplasmosis.
The incubation period of equine piroplasmosis varies from 5 to 21 days.110, 117, 146, 149, 172 A rare, peracute form of the disease resulting in horses being found either dead or moribund, has been reported in South Africa.110 Acute cases are characterized by a fever, usually exceeding 40 °C, varying degrees of anorexia and malaise, and elevated respiratory and pulse rates. Fever is often accompanied by sweating, congestion of mucous membranes, tachycardia and palpitating cardiac sounds. The faecal balls are smaller and drier than normal and are yellowish-green.
Subacute cases show varying degrees of anorexia and malaise, weight loss, an elevated or normal rectal temperature, and increased pulse and respiratory rates. Heart rates of 60 beats per minute may be accompanied by medium-grade systolic murmurs. The fever is sometimes more intermittent in Theileria equi than in Babesia caballi infections.110 The mucous membranes may vary from pale-pink or pale-yellow to bright yellow. Petechiae or ecchymoses may also be visible on the mucous membranes. Normal bowel movements are sometimes slightly depressed, and the animal may show signs of colic, such as pawing, looking at the flanks and lying down. The faecal balls are smaller and firmer in consistency than normal and are coated with a thin layer of mucus. Constipation may be followed by diarrhoea. The urine is often dark yellow to orange or even brown, but in some cases it is reddish-brown as a result of haemoglobin and bile pigments.34, 68 Rectal examination usually reveals an enlarged spleen. Untreated or neglected cases become severely anaemic and show signs of general weakness, such as drooping of the head and neck, stumbling, and muscle trembling, swaying and lying down. There may be a mild oedematous swelling of the distal parts of limbs and marked preputial oedema,110 but oedema of the head, limbs and ventral abdomen has not been observed in horses suffering only from piroplasmosis in South Africa although this has been reported in other countries.96, 183 African horse sickness or infestations of helminths occurring concurrently with equine piroplasmosis may explain atypical clinical signs, such as oedema of the supraorbital fossae and oedema of the ventral abdomen and thorax, sometimes associated with the disease. Clinical signs are apparently less severe at ambient temperatures below 15 °C.167
Chronic cases usually present with a history of nonspecific clinical signs including mild inappetance, poor performance and a drop in body weight. Some cases reveal pale-pink mucous membranes and mild tachycardia. The spleen is usually enlarged.
Experimental infection of horses with Theileria equi or Babesia caballi often results in a subclinical form of the disease.39, 101 Equids with intact spleens are able to control Theileria equi and Babesia caballi infections; however, splenectomized animals develop high levels of parasitaemia and eventually succumb to the infection. Parasitaemia in these animals is usually accompanied by a drop in packed cell volume (PCV) and platelet count. The PCV typically drops to 20 per cent but may even reach 10 per cent or lower.8
Neonatal piroplasmosis in foals is characterized by weakness at birth or the rapid onset of listlessness and the development of anaemia, severe icterus and malaise soon thereafter, often prior to the ingestion of colostrum.49 Affected foals become progressively lethargic and are ultimately unable to stand on their own or to suckle. There is usually a fever and petechiae may be evident in the mucous membranes. Some foals, however, are apparently normal at birth, but develop signs of the disease two to three days later. Nervous signs are rarely seen in equine piroplasmosis.73 Marked ataxia, generalized trembling and mild to moderate tonic-clonic spasms have been observed in young foals associated with high rectal temperatures and positive Babesia equi smears.180
A variety of complications have been described in equine piroplasmosis. Acute renal failure causing marked elevation in serum urea and creatinine concentrations have been observed.180 Some horses may show signs of colic and enteritis.68, 180 The prognosis is poor when the latter occurs together with laminitis. Pneumonia may develop.167 In stallions, partial or complete loss of fertility, temporary or permanent, has been reported.110 Mares may abort at any stage of pregnancy as a result of systemic disease and pyrexia, but often there is no history of previous illness in mares that abort; abortion occurs most commonly in the last three months of gestation after intra-uterine infection45, 110 and is generally accompanied by simultaneous expulsion of the placenta. Uterine involution is normal and subsequent conception is not affected.
Pathology
Clinical pathology
Reduction in the haemoglobin concentration and in red blood cell and platelet counts are typical of Theileria equi and Babesia caballi infections. Acute infections are characterized by lymphopenia and neutropenia.148 Neutrophilia and lymphopenia have been reported in splenectomized donkeys.135
Decreased plasma fibrinogen concentrations and platelet counts,5 as well as elevated bilirubin concentrations, have been reported in horses suffering from piroplasmosis. Peaks in parasitaemia are accompanied by varying degrees of thrombocytopenia, hypophosphataemia, hypoferronaemia as well as bilirubinaemia.39 In splenectomized horses, the PCV typically drops to 20 per cent but may even reach 10 per cent or lower.8
Varying degrees of haemoglobinuria are also present. The serum of horses suffering from haemoglobinuric nephrosis is characterized by low sodium and chloride concentrations, and elevated urea and creatinine concentrations. There is a drop in the specific gravity of the urine.180
Macro- and microscopical pathology
Gross pathological findings include anaemia and icterus; oedema of subcutaneous and subserosal tissues; varying degrees of emaciation; hepatomegaly and splenomegaly; enlarged pale or, in haemoglobinuric cases, red-brown kidneys with subcapsular and cortical haemorrhages; ascites, hydrothorax and hydropericardium with epi- and endocardial haemorrhages; congestion and oedema of the lungs; and enlargement of the lymph nodes. Catarrhal enteritis, myocardial degeneration, peri- or epicarditis and pneumonia have also been recorded.110
Histopathological findings include congestion and oedema of the lungs, and fatty changes and bile stasis in the liver. The nephrosis is characterized by hydropic and fatty degeneration of the tubular epithelium, and by protein and haemoglobin casts in many tubules in the cortex and medulla. Congestion, haemosiderosis, and depletion of lymphocytes are observed in the spleen.117, 149 In addition to these changes, marked proliferation of reticulo-endothelial cells in the liver, kidneys, lungs and lymph nodes is evident. Thrombi in the blood vessels of the liver and lungs have been reported in splenectomized horses.117
Foetuses aborted relatively early in gestation are usually moderately to severely autolysed. The lesions in aborted foetuses and neonatal foals include anaemia, moderate to severe icterus (Figure 3), petechiae on visceral and serosal surfaces, hydrothorax, congestion and oedema of the lungs, splenomegaly and hepatomegaly (Figure 4). The microscopic changes are very similar to those in adult animals. While the parasitaemia in adult animals that die of the disease is usually low, it may often be more than 50 per cent in aborted foetuses and neonatal foals (Figure 5). The placenta is often oedematous and contains scattered small haemorrhages or large haemorrhagic patches. Many of the red blood cells in the placenta are parasitized.
Diagnosis
The clinical signs of equine piroplasmosis are often nonspecific, making it easy to confuse the disease with a variety of others (see Differential Diagnosis). It is also not possible to distinguish between Theileria equi and Babesia caballi infections based on clinical signs alone and mixed infections do occur.36 Several techniques have thus been developed for the diagnosis of equine piroplasmosis. These include direct demonstration of parasites in blood smears, serological assays, cell-culture techniques, xenodiagnosis, DNA probes and several different conventional, nested and real-time PCR assays.
During acute stages of infection, parasites can be detected microscopically by preparing a thin blood smear stained with Giemsa or Diff-Quik®. In peracute, acute and subacute piroplasmosis it is often difficult to demonstrate the parasites in thin blood smears as parasitaemias are often very low (<0,1 per cent) and parasites may be difficult to find.150 In such instances, the thick blood smear technique116 is useful in detecting parasites.150 The parasites can easily be distinguished from each other. Babesia caballi is generally larger than Theileria equi and typically appears as two large pear-shaped merozoites that measure 2 to 5 μm in length.36 Theileria equi merozoites occur within erythrocytes as four pear-shaped parasites arranged in a distinct maltese cross formation generally measuring 2 to 3 μm.36
Due to the difficulties experienced in detecting low numbers of parasites by microscopy in subclinically infected or carrier animals, serological testing of horses is recommended by the OIE as the preferred method of determining freedom from infection for animals destined to be imported into countries where the disease does not occur. Serological methods such as the complement fixation test (CFT), indirect fluorescent antibody test (IFAT), Western immunoblot and competitive enzyme-linked immunosorbent assay (cELISA) have thus been developed to aid in the diagnostic process.87, 94, 136 Currently, the IFAT and the cELISA are the prescribed tests used for qualifying horses free from infection.
The CFT, which was previously regarded as the official regulatory test, relies on the fixation of complement during a reaction between specific antigen and antibody.22, 23, 54, 59, 74 The test does have some drawbacks in that, although it is very specific for acute infections, the sensitivity of the assay decreases in the case of chronic infections, as some antibody types that develop during chronic infections do not fix complement.108 Additionally, cross-reactivity between Theileria equi and Babesia caballi antibodies has been reported when using the CFT.23, 92
The IFAT is considered to be more sensitive than the CFT and it can be used to distinguish between Theileria equi and Babesia caballi infections.23, 59 Parasite antigens that are fixed to glass sides are allowed to react with test sera. Fluorescently labelled antibodies react with antigens that are bound to the glass slide and strong fluorescence signals observed at a dilution of 1:80 or higher are considered positive. Although recognizing a strong positive IFAT result is simple, differentiation between weak positive and negative reactions can be difficult. Despite these limitations, the IFAT remains one of the prescribed tests for equine piroplasmosis.
Recombinant Theileria equi and Babesia caballi merozoite proteins and monoclonal antibodies to these proteins have subsequently been used in the development of competitive inhibition ELISAs (cELISA).87, 94 Since 2004, cELISA assays for Theileria equi and Babesia caballi have been listed as regulatory tests prescribed by the OIE for the international movement of horses. Equi merozoite antigen-1 (EMA-1) is a surface-exposed, immunodominant protein expressed during the T. equi merozoite stage. A competitive-inhibition ELISA (cELISA) employing a monoclonal antibody to recombinant EMA-1 has been shown to reliably detect antibody to T. equi in the sera of infected horses from several different countries.93 Although the official cELISA regulatory test for Theileria equi was able to detect antibody to Theileria equi in sera of infected horses from South Africa, discrepancies were observed between IFAT and cELISA test results. These differences could suggest that there may be heterogeneity in the EMA-1 epitopes of some South African isolates, the occurrence of which may be related to antigenic variability and pathogenicity.18 Similarly, genetically distinct Theileria equi stains recently detected in the U.S. were found to be weakly seropositive using the cELISA assay but negative by quantitative real-time PCR, thus calling the validity of cELISA results into question.66
The OIE recommended cELISA assay for Babesia caballi relies on the recognition of an epitope on BC48 (RAP-1).87 The assay has been reported to be superior to the CFT in the detection of Babesia caballi antibody in the sera of equine samples across the world.87 However, recent studies have shown that the lack of RAP-1 sequence conservation in both South African19 and Israeli144 isolates prevents the cELISA from detecting all infected horses. Furthermore, inconsistencies observed between infection status and RAP-1 cELISA serology results were also reported for horses in the U.S.11 A high proportion of sero-positive horses detected using the RAP-1 cELISA were confirmed to be Babesia caballi negative using immunoblots, based on the observed banding patterns. Researchers reported that reactions to a single ~ 50 kDa protein is indicative of the absence of a Babesia caballi infection, while multiple banding patterns between 30 to 50 kDa suggested a Babesia caballi infection.11
The Western blot (immunoblot) assay, which was primarily used in research settings, has recently been introduced as an adjunct diagnostic tool for the detection of Babesia caballi infection by the National Veterinary Services Laboratory in Ames, Iowa and validation of the test for detecting Theileria equi is underway.188
Several different polymerase chain reaction (PCR) tests have been developed for the detection of Theileria equi and Babesia caballi parasite DNA.3, 4, 13, 17, 18, 129, 177 These tests have been reported to have higher sensitivities and specificities than serological assays. The reported detectable parasitaemias using conventional PCR assays based on species-specific oligonucleotide primers within the 18S rRNA gene were approximately 0.000083 per cent for Theileria equi and 0.017 per cent for Babesia caballi.13 Nested PCR based on the Theileria equi EMA-1 gene had a sensitivity of 0.000006 per cent parasitaemia.129 Several quantitative real-time PCR assays based on the 18S rRNA ribosomal RNA gene17, 89 as well as the antigen genes, RAP-1 and EMA-1,18, 67, 177 have also been developed. However, reports of genetic variation between stains of Theileria equi isolates globally make the standardization of PCR as a diagnostic test challenging, and currently, PCR is only used in research settings.
Differential diagnosis
The clinical signs of equine piroplasmosis are often nonspecific, and the disease may be confused with a variety of conditions that include surra, equine infectious anemia, African horse sickness, equine ehrlichiosis, equine viral arteritis virus, leptospiriosis and red maple leaf toxicity.
In the febrile stage of equine influenza before typical clinical signs have developed, it may be difficult to differentiate from piroplasmosis.
A low percentage of horses suffering from equine encephalosis may exhibit fever and mild icterus, which should be differentiated from those occurring as a result of equine piroplasmosis.88 The development of anaemia and icterus in horses showing classical signs of African horse sickness should prompt the examination of blood smears for Babesia parasites, since concurrent infections do occur.68 Equine infectious anaemia, which has not been reported in southern Africa, may be very difficult to differentiate clinically from equine piroplasmosis.
In the new-born foal, piroplasmosis should be differentiated from both equid herpesvirus-1 infection and iso-erythrolytic neonatal icterus (iso-immune erythrolysis). The latter occurs within a few days of the ingestion of colostrum and is often afebrile.
Abortions as a result of piroplasmosis most often occur when pregnant mares are affected after the fifth or sixth month of gestation, and should be differentiated from other potential causes of abortion such as equid herpesvirus-1.
Control
A wide variety of drugs have been used to treat equine piroplasmosis with varying success. In endemic regions. The purpose of treatment is to decrease clinical signs and accelerate recovery from either parasite infection. Non-endemic countries need to remain piroplasm free and the purpose of treatment in these countries is to eliminate all transmission risk, i.e. chemosterilization Theileria equi infections are generally considered much more difficult to eliminate that Babesia caballi infections, which have long been considered self-limiting.
The acridine dyes (euflavine and others), at a recommended dose of 4 to 8 ml/100 kg body weight of a 5 per cent solution with a maximum dose of 20 ml, administered i/v very carefully,25 are effective against both Theileria equi and Babesia caballi, but these drugs are no longer used. Subcutaneous administration of these dyes cause severe irritation of the tissues at the site of injection. Resistance of T. equi to euflavine has been reported.49 The simultaneous i/m administration of atropine is recommended to counteract the potential adverse parasympathomimetic effects (primarily abdominal pain) of imidocarb diproprionate and euflavine.181
The bisazo dye, trypan blue, administered in a single dose of 150 to 200 ml i/v of a 2 per cent solution, only has an effect on B. caballi.11 This drug also has the disadvantage of producing a discolouration of many of the animal’s tissues. For this reason, and because more effective drugs have been developed, it is now rarely used.
Tetracyclines such as chlortetracycline hydrochloride and oxytetracycline hydrochloride are effective only against Theileria equi when given i/v daily for seven days at a dosage rate of at least 5,5 mg/kg body weight.85
Preliminary results indicate that parvaquone, an antitheilerial drug, can be effective in the treatment of acute Theileria equi infections in horses,102 but it does not eliminate infection.191
The drugs commonly used to treat equine piroplasmosis in equids are imidocarb and diminazene. Imidocarb, a carbanilide derivative, is typically administered to horses intramuscularly (i/m). Imidocarb is available in two forms, the diproprionate salt form (Imidocarb diproprionate, ID) and the dihydrochloride salt form. Although several drugs have been used to decrease clinical signs of infection, imidocarb in its diproprionate (ID) form is considered the most effective.187 The dihydrochloride salt form of the drug causes severe muscle damage at the site of injection.52, 123 During the recent outbreak in Texas, chemo-sterilization of Theileria equi infections was demonstrated with appropriate dosing of imidocarb diproprionate.176 Doses for alleviating clinical signs range from 2.2 to 4.4 mg/kg, administered once, i/m.52, 100, 158, 176 For chemosterilization of both Theileria equi and Babesia caballi infections, four treatments with 4.4 mg/kg, administered i/m every 72 hours is recommended.64, 158, 176 Clearance is demonstrated by negative PCR and serology results as well as the inability to transmit the parasite to a naïve splenectomized horse via blood transfusions.176
Horses undergoing treatment with imidocarb diproprionate need to be carefully monitored for complications. Adverse reactions to treatment include agitation, sweating, cholic and diarrhoea.123 Atropine (0.2 mg/kg) or glycopyrrolate (0.0025 mg/kg) have been used to prevent these adverse reactions. However the long-lasting effects of these drugs have also been shown to have detrimental anticholinergic side effects. The use of a shorter-acting anticholinergic drug, n-butylscopolamine (Buscopan, Boehringer Ingelheim, Animal Health GmbH, Ingelheim, Germany), before the administration of imidocarb diproprionate can reduce the onset of adverse reactions.176
Diminazene aceturate and dimenazene diaceturate, administered at a dose of 3.5 mg/kg i/m every 48 hours for two treatments, have been used successfully against both Theileria equi and Babesia caballi infections. However, no incidences of chemosterilization have as yet been reported and these drugs cause severe muscle damage at the injection site.145 Toxic doses result in respiratory distress, depression and other signs of intoxication.166
Depending on the severity of the disease, supportive therapy is often necessary and may include blood and/or fluid infusions and i/v administration of essential phospholipids and antibiotics. Polyionic electrolyte infusions may be considered for severely dehydrated horses showing anorexia or suffering from diarrhoea. Oral laxatives may also be indicated.
In endemic countries, in highly intensive management systems where animals receive daily individual care, it is probably feasible to control the disease by eliminating the contact between the tick vector and equine host by means of the regular application of an acaricide. However, in free-ranging systems it is difficult, if not impossible, to control these multi-host tick vectors effectively. Strategic tick control will expose foals to ticks and allow them to develop immunity early in life, which will result in endemic stability. In non-endemic countries, the movement of horses from endemic to non-endemic regions is tightly regulated to prevent entrance of positive horses. Regulations require that horses test negative for both parasites using the recommended serological test. Positive horses are generally denied entrance, unless they are participating in athletic events. Prior to movement from endemic to non-endemic regions, horses undergo acaricide treatment to remove any ticks. Once they arrive in non-endemic countries, they undergo strict quarantine and are again thoroughly examined for tick infestation.
No vaccine is as yet available, and therefore fully susceptible animals introduced into endemic areas should be carefully monitored and treated when necessary.
References
- ABEDI, V., RAZMI, G., SEIFI, H., NAGHIBI, A., 2014. Molecular and serological detection of Theileria equi and Babesia caballi infection in horses and ixodid ticks in Iran. Ticks and Tick-borne Diseases, 5, 239-244.
- AHARONSON-RAZ, K., RAPOPORT, A., HAWARI, I.M., LENSKY, I.M., BERLIN, D., ZIVOTOFSKY, D., KLEMENT, E., STEINMAN, A., 2014. Novel description of force of infection and risk factors associated with Theileria equi in horses in Israel and in The Palestinian Authority. Ticks and Tick-borne Diseases 5, 366-372.
- ALHASSAN, A., PUMIDONMING, W., OKAMURA, M., HIRATA, H., BATTSETSEG, B., FUJISAKI, K., YOKOYAMA, N., IGARASHI, I., 2005. Development of a single-round and multiplex PCR method for the simultaneous detection of Babesia caballi and Babesia equi in horse blood. Veterinary Parasitology 129, 43-49.
- ALHASSAN, A., THEKISOE, O.M., YOKOYAMA, N., INOUE, N., MOTLOANG, M.Y., MBATI, P.A., YIN, H., KATAYAMA, Y., ANZAI, T., SUGIMOTO, C., IGARASHI, I., 2007. Development of loop-mediated isothermal amplification (LAMP) method for diagnosis of equine piroplasmosis. Veterinary Parasitology 143, 155-160.
- ALLEN, P.C., FRERICHS, W.M. & HOLBROOK, A.A., 1975. Experimental acute Babesia caballi infections. II. Response of platelets and fibrinogen. Experimental Parasitology, 37, 373–379.
- ALLSOPP, M.T., LEWIS, B.D., PENZHORN, B.L., 2007. Molecular evidence for transplacental transmission of Theileria equi from carrier mares to their apparently healthy foals. Veterinary Parasitology 148, 130-136.
- ALLSOPP, M.T.E.P., 1994. The phylogeny of Babesia, Theileria and related parasites and the development of species specific probes for diagnostic purposes. PhD thesis, Faculty of Biochemistry, University of the Witwatersrand, South Africa.
- AMBAWAT, H.K., MALHOTRA, D.V., KUMAR, S., DHAR, S., 1999. Erythrocyte associated haemato-biochemical changes in Babesia equi infection experimentally produced in donkeys. Veterinary Parasitology 85, 319-324.
- ANON, 1996. Equine prioplasmosis. In: Manual of Standards for Diagnostic Tests and Vaccines. List A and B Diseases of Mammals, Birds and Bees. Office International des Epizooties. World Organisation of Animal Health, 420–425.
- ATKINSON, R., 1977. Importation in shambles. Equus, 2, 14–22.
- AWINDA, P.O., MEALEY, R.H., WILLIAMS, L.B., CONRAD, P.A., PACKHAM, A.E., REIF, K.E., GRAUSE, J.F., PELZEL-MCCLUSKEY, A.M., CHUNG, C., BASTOS, R.G., KAPPMEYER, L.S., HOWE, D.K., NESS, S.L., KNOWLES, D.P., UETI, M.W., 2013. Serum antibodies from a subset of horses positive for Babesia caballi by competitive enzyme-linked immunosorbent assay demonstrate a protein recognition pattern that is not consistent with infection. Clinical and Vaccine Immunology 20, 1752-1757.
- BAPTISTA, C., LOPES, M.S., TAVARES, A.C., ROJER, H., KAPPMEYER, L., MENDONCA, D., DA CAMARA MACHADO, A., 2013. Diagnosis of Theileria equi infections in horses in the Azores using cELISA and nested PCR. Ticks and Tick-borne Diseases 4, 242-245.
- BASHIRUDDIN, J.B., CAMMA, C., REBELO, E., 1999. Molecular detection of Babesia equi and Babesia caballi in horse blood by PCR amplification of part of the 16S rRNA gene. Veterinary Parasitology 84, 75-83.
- BECK, R., VOJTA, L., MRLJAK, V., MARINCULIC, A., BECK, A., ZIVICNJAK, T., CACCIO, S.M., 2009. Diversity of Babesia and Theileria species in symptomatic and asymptomatic dogs in Croatia. International Journal for Parasitology 39, 843-848.
- BHOORA, R., BUSS, P., GUTHRIE, A.J., PENZHORN, B.L., COLLINS, N.E., 2010a. Genetic diversity of piroplasms in plains zebra (Equus quagga burchellii) and Cape mountain zebra (Equus zebra zebra) in South Africa. Veterinary Parasitology 174, 145-149.
- BHOORA, R., FRANSSEN, L., OOSTHUIZEN, M.C., GUTHRIE, A.J., ZWEYGARTH, E., PENZHORN, B.L., JONGEJAN, F., COLLINS, N.E., 2009. Sequence heterogeneity in the 18S rRNA gene within Theileria equi and Babesia caballi from horses in South Africa. Veterinary Parasitology 159, 112-120.
- BHOORA, R., QUAN, M., FRANSSEN, L., BUTLER, C.M., VAN DER KOLK, J.H., GUTHRIE, A.J., ZWEYGARTH, E., JONGEJAN, F., COLLINS, N.E., 2010b. Development and evaluation of real-time PCR assays for the quantitative detection of Babesia caballi and Theileria equi infections in horses from South Africa. Veterinary Parasitology 168, 201-211.
- BHOORA, R., QUAN, M., MATJILA, P.T., ZWEYGARTH, E., GUTHRIE, A.J., COLLINS, N.E., 2010c. Sequence heterogeneity in the equi merozoite antigen gene (ema-1) of Theileria equi and development of an ema-1-specific TaqMan MGB assay for the detection of Theileria equi. Veterinary Parasitology 172, 33-45.
- BHOORA, R., QUAN, M., ZWEYGARTH, E., GUTHRIE, A.J., PRINSLOO, S.A., COLLINS, N.E., 2010d. Sequence heterogeneity in the gene encoding the rhoptry-associated protein-1 (RAP-1) of Babesia caballi isolates from South Africa. Veterinary Parasitology 169, 279-288.
- BOLDBAATAR, D., XUAN, X., BATTSETSEG, B., IGARASHI, I., BATTUR, B., BATSUKH, Z., BAYAMBAA, B., FUJISAKI, K., 2005. Epidemiological study of equine piroplasmosis in Mongolia. Veterinary Parasitology 127, 29-32.
- BÖSE, R., JORGENSEN, W. K., DALGLIESH, R. J., FRIEDHOFF, K. T. & DE VOS, A. J., 1995. Current state and future trends in the diagnosis of babesiosis. Veterinary Parasitology, 57, 61–74.
- BROWN, G.M., 1979. Equine Piroplasmosis Complement Fixation Test Antigen Production. USDA, APHIS, National Veterinary Services Laboratories. Diagnostic Reagents Laboratory, Ames, Iowa. NCSL Diagnostic Production.
- BRUNING, A., 1996. Equine piroplasmosis an update on diagnosis, treatment and prevention. British veterinary journal 152, 139-151.
- BRUNING, A., PHIPPS, P., POSNETT, E. & CANNING, E.U., 1997. Monoclonal antibodies against Babesia caballi and Babesia equi and their application in serodiagnosis. Veterinary Parasitology, 68, 11–26.
- CALLOW, L.L., 1984. Animal Health in Australia. Protozoal and Rickettsial diseases. Canberra: Australian Bureau of Animal Health. Australian Government Publishing Service, 5.
- CALLOW, L.L., MCGREGOR, W., RADWELL, B.J., FRASER, G.C., MAHONEY, D.F. & ROBERTSON, G.M., 1979. Evaluation of an indirect fluorescent antibody test to diagnose Babesia equi infections in horses. Australian Veterinary Journal, 55, 555–559.
- CAMACHO, A.T., GUITIAN, F.J., PALLAS, E., GESTAL, J.J., OLMEDA, A.S., HABELA, M.A., TELFORD, S.R., 3rd. & SPIELMAN, A., 2005. Theileria (Babesia) equi and Babesia caballi infections in horses in Galicia, Spain. Tropical Animal Health and Production 37, 293-302.
- CANTU-MARTINEZ, M.A., SEGURA-CORREA, J.C., SILVA-PAEZ, M.L., AVALOS-RAMIREZ, R., WAGNER, G.G., 2012. Prevalence of antibodies to Theileria equi and Babesia caballi in horses from northeastern Mexico. Journal of Parasitology 98, 869-870.
- CARBREY, E.A., AVERY, R.J., KNOWLES, R.C. & SASH, S.C., 1971. Chemotherapy of equine babesiosis. Journal of the American Veterinary Medical Association, 159, 1538–1545.
- CHHABRA, S., RANJAN, R., UPPAL, S.K., SINGLA, L.D., 2012. Transplacental transmission of Babesia equi (Theileria equi) from carrier mares to foals. Journal of parasitic diseases 36, 31-33.
- CRIADO-FORNELIO, A., MARTINEZ-MARCOS, A., BULING-SARANA, A., BARBA-CARRETERO, J.C., 2003. Molecular studies on Babesia, Theileria and Hepatozoon in southern Europe. Part II. Phylogenetic analysis and evolutionary history. Veterinary Parasitology 114, 173-194.
- DE KOCK, G.D.W., 1920. Drug treatment in nuttalliosis. 7th & 8th Report of the Director of Veterinary Research, Union of South Africa, 639–675.
- DE WAAL, D.T. & POTGIETER, F.T., 1987. The transstadial transmission of Babesia caballi by Rhipicephalus evertsi evertsi. Onderstepoort Journal of Veterinary Research, 54, 655–656.
- DE WAAL, D.T., 1983–1998. Parasitology Division, Onderstepoort Veterinary Institute, Unpublished data.
- DE WAAL, D.T., 1990. The transovarial transmission of Babesia caballi by Hyalomma truncatum. Onderstepoort Journal of Veterinary Research, 57, 99–100.
- DE WAAL, D.T., 1992. Equine piroplasmosis: a review. British veterinary journal 148, 6-14.
- DE WAAL, D.T., 1995. Distribution, transmission and serodiagnosis of Babesia equi and Babesia caballi in South Africa. PhD thesis, Faculty of Veterinary Sience, University of Pretoria, South Africa.
- DE WAAL, D.T., HORN, E. & JOSEMANS, A.I., 1999. Epidemiology of equine piroplasmosis in South Africa: Detection and duration of colostral antibodies and the incidence of new infections in foals. Proceedings of the 8th Equine Infectious Diseases Conference, Dubai, United Arab Emirates, 23–26 March 1998.
- DE WAAL, D.T., VAN HEERDEN, J. & POTGIETER, F.T., 1987. A preliminary investigation into the clinical pathological changes and serological response in horses experimentally infected with Babesia equi and Babesia caballi. Onderstepoort Journal of Veterinary Research, 54, 561–568.
- DE WAAL, D.T., VAN HEERDEN, J., POTGIETER, F.T., 1987. An investigation into the clinical pathological changes and serological response in horses experimentally infected with Babesia equi and Babesia caballi. Onderstepoort Journal of Veterinary Research 54, 561-568.
- DE WAAL, D.T., VAN HEERDEN, J., VAN DEN BERG, S.S., STEGMANN, G.F., POTGIETER, F.T., 1988. Isolation of pure Babesia equi and Babesia caballi organisms in splenectomized horses from endemic areas in South Africa. Onderstepoort Journal of Veterinary Research 55, 33-35.
- DONNELLAN, C.M., MARAIS, H.J., 2009. Equine Piroplasmosis, In: Mair, T.S., Hutchinson, R.E. (ed.). Infectious diseases of the horse. EVJ Ltd, Cambridgeshire, England, UK, 333-340.
- DONNELLY, J., JOYNER, L.P., GRAHAM-JONES, O. & ELLIS, C.P., 1980. A comparison of the complement fixation and immunofluorescent antibody test in a survey of the prevalence of Babesia equi and Babesia caballi in horses in the sultanate of Oman. Tropical Animal Health and Production, 12, 50–60.
- DONNELLY, J., PHIPPS, L.P. & WATKINS, K.L., 1982. Evidence of maternal antibodies to Babesia equi and Babesia caballi in foals of seropositive mares. Equine Veterinary Journal, 14, 126–128.
- DU PLESSIS, J.L. & BASSON, P.A., 1966. Babesiosis in aborted equine foetuses: A report on two cases in South Africa. Journal of the South African Veterinary Association, 37, 267–269.
- ENIGK, K., 1943. Die Überträger des Pferdepiroplasmose, ihre Verbreitung und Biologie. Archiv für Wissenschaftliche und Praktische Tierheilkunde, 78, 209–240.
- ENIGK, K., 1944. Weitere Untersuchungen zur Uberträgerfrage der Pferdepiroplasmose. Archiv für Wissenschaftliche und Praktische Tierheilkunde, 79, 58–60.
- ERASMUS, B.J., 1988. Veterinary Research Institute, Onderstepoort. Unpublished data.
- ERBSLÖH, J.K.E., 1975. Babesiosis in the newborn foal. Journal of Reproduction and Fertility, 23, 725–726.
- FARKAS, R., TANCZOS, B., GYURKOVSZKY, M., FOLDVARI, G., SOLYMOSI, N., EDELHOFER, R., HORNOK, S., 2013. Serological and molecular detection of Theileria equi infection in horses in Hungary. Veterinary Parasitology 192, 143-148.
- FRANCA, C., 1909. Sur la classification des piroplasmes et description de deux formes de ces parasites. Arquiv Instituto Bacteriologico Camera Pestana, 3, 11–18.
- FRERICHS, W.M. & HOLBROOK, A.A., 1974. Feeding mechanisms of Babesia equi. Journal of Protozoology, 2, 707–709.
- FRERICHS, W.M., ALLEN, P.C. & HOLBROOK, A.A., 1973. Equine piroplasmosis (Babesia equi): Therapeutic trials of imidocarb dihydrochloride in horses and donkeys. The Veterinary Record, 93, 73–75.
- FRERICHS, W.M., HOLBROOK, A.A. & JOHNSON, A.J., 1969. Equine piroplasmosis: Complement fixation titres of horses infected with Babesia caballi. American Journal of Veterinary Research, 30, 697–702.
- FRIEDHOFF, K. & BÖSE, R., 1994. Recent developments in diagnostics of some tick-borne diseases. In: UILENBERG, G., PERMIN, A. & HANSEN, J.W., (eds). Use of Applicable Biotechnological Methods for Diagnosing Haemoparasites. Proceedings of the Expert Consultation, Merida, Mexico, 4–6 October 1993, FAO, Rome, Italy, 46–57.
- FRIEDHOFF, K.T. & BÜSCHER, C., 1976. Rediscovery of Koch’s Strahlenkorper of Babesia bigemina. Zeitschrift für Parasitenkunde, 50, 345–347.
- FRIEDHOFF, K.T., 1981. Morphologic aspects of Babesia in the tick. In: RISTIC, M. & KREIER, J.P., (eds). Babesiosis. New York: Academic Press.
- FRIEDHOFF, K.T., 1982. Die piroplasmen der Equiden-Bedeutung für den Internationalen Pferdeverkehr. Berliner und Münchener Tierärtzliche Wochenschrift, 95, 368–374.
- FRIEDHOFF, K.T., SOULE, C., 1996. An account on equine babesioses. Revue Scientifique et Technique, 15, 1191-1201.
- FRIEDHOFF, K.T., TENTER, A.M., MULLER, I., 1990. Haemoparasites of equines: impact on international trade of horses. Revue Scientifique et Technique 9, 1187-1194.
- GEORGES, K.C., EZEOKOLI, C.D., SPARAGANO, O., PARGASS, I., CAMPBELL, M., D'ABADIE, R., YABSLEY, M.J., 2011. A case of transplacental transmission of Theileria equi in a foal in Trinidad. Veterinary Parasitology 175, 363-366.
- GÖTZ, F., 1982. Untersuchungen über die Brauchbarkeit von ELISA, IFA, IHA under KBR zum nachweis von Babesia equi Infectionen. Inaugural Dissertation aus dem Institut für Vergleichende Tropenmedizin und Parasitologie der Tierärztlichen Fakultät der Universität München, 1–40.
- GRANDI, G., MOLINARI, G., TITTARELLI, M., SASSERA, D., KRAMER, L.H., 2011. Prevalence of Theileria equi and Babesia caballi infection in horses from northern Italy. Vector Borne and Zoonotic Diseases 11, 955-956.
- GRAUSE, J.F., UETI, M.W., NELSON, J.T., KNOWLES, D.P., KAPPMEYER, L.S., BUNN, T.O., 2013. Efficacy of imidocarb dipropionate in eliminating Theileria equi from experimentally infected horses. Veterinary Journal 196, 541-546.
- GUIMARAES, A. M., LIMA, J. D. & RIBEIRO, M. F., 1998. Sporogony and experimental transmission of Babesia equi by Boophilus microplus. Parasitology Research, 84, 323–327.
- HALL, C.M., BUSCH, J.D., SCOLES, G.A., PALMA-CAGLE, K.A., UETI, M.W., KAPPMEYER, L.S., WAGNER, D.M., 2013. Genetic characterization of Theileria equi infecting horses in North America: evidence for a limited source of U.S. introductions. Parasitilogy Vectors 6, 35.
- HEIM, A., PASSOS, L.M., RIBEIRO, M.F., COSTA-JUNIOR, L.M., BASTOS, C.V., CABRAL, D.D., HIRZMANN, J., PFISTER, K., 2007. Detection and molecular characterization of Babesia caballi and Theileria equi isolates from endemic areas of Brazil. Parasitology Research 102, 63-68.
- HENNING, M.W., 1956. Animal Diseases in South Africa. 3rd edition. South Africa: Central News Agency, Ltd.
- HEUCHERT, C.M., DE GIULLI, V., JR., DE ATHAIDE, D.F., BOSE, R., FRIEDHOFF, K.T., 1999. Seroepidemiologic studies on Babesia equi and Babesia caballi infections in Brazil. Veterinary Parasitology 85, 1-11.
- HOLAN, M., 1983. Vergleichende Untersuchungen der Feinstruktur von Babesia caballi (Nuttall, 1910) und Babesia equi (Laveran, 1901). Inaugural Dissertation aus dem Institut für Vergleichende Tropenmedizin und Parasitologie der Tierärztlichen Fakultät der Universität München, 1–56.
- HOLBROOK, A.A. & FRERICHS, W.M., 1968. Equine piroplasmosis. Proceedings of the 72nd Annual Meeting of the United States Animal Health Association, New Orleans, Los Angeles.
- HOLBROOK, A.A., 1965. Equine piroplasmosis and its diagnosis. Proceedinqs of the Eleventh Annual Convention of the American Association of Equine Practitioners, Miami Beach, Florida.
- HOLBROOK, A.A., ANTHONY, O.W. & JOHNSON, A.J., 1968. Observations on the development of Babesia caballi (Nuttall) in the tropical horse tick Dermacentor nitens Neumann. Journal of Protozoology, 15, 391–396.
- HOLBROOK, A.A., COOPERRIDER, D.E., ROBY, T.O., KIRKHAM, M.W. & MARTIN, W.H., 1971. Protocol for the complement fixation test for equine piroplasmosis. Proceedings of the 75th Annual Meeting of the United States Animal Health Association, Oklahoma City, Oklahoma.
- HOLBROOK, A.A., FRERICHS, W.M. & ALLEN, P.C., 1973. Laboratory diagnosis of equine piroplasmosis. Proceedings of the Third International Conference on Equine Infectious Diseases, Paris: Karger, S., Basel.
- HOLBROOK, A.A., JOHNSON, A.J. & MADDEN, P.A., 1968. Equine piroplasmosis: Intraerythrocytic development of Babesia caballi (Nuttall) and Babesia equi. American Journal of Veterinary Research, 29, 297–303.
- HOLMAN, P.J., BECU, T., BAKOS, E., POLLEDO, G., CRUZ, D. & WAGNER, G.G., 1998. Babesia equi field isolates cultured from horse blood using a microcentrifuge method. Journal of Parasitology, 84, 696–699.
- HOLMAN, P.J., FRERICHS, W.M., CHIEVES, L. & WAGNER, G.G., 1993. Culture confirmation of the carrier status of Babesia caballi-infected horses. Journal of Clinical Microbiology, 31, 698–701.
- HORNOK, S., EDELHOFER, R., FOLDVARI, G., JOACHIM, A., FARKAS, R., 2007. Serological evidence for Babesia canis infection of horses and an endemic focus of Babesia caballi in Hungary. Acta Veterinaria Hungarica 55, 491-500.
- HUTCHEON, D., 1883. Biliary fever. Report of the Colonial Veterinary Surgeon, 32–37.
- HUTCHEON, D., 1885. Biliary fever of the horse. Report of the Colonial Veterinary Surgeon, 26–28.
- HUTCHEON, D., 1890. Biliary fever or jaundice in the horse. Agricultural Journal of the Cape of Good Hope, 2, 361–362.
- HUTCHEON, D., 1895. Biliary fever. Agricultural Journal of the Cape of Good Hope, 8, 17–18.
- IKADAI, H., NAGAI, A., XUAN, X., IGARASHI, I., TSUGIHIKO, K., TSUJI, N., OYAMADA, T., SUZUKI, N., FUJISAKI, K., 2002. Seroepidemiologic studies on Babesia caballi and Babesia equi infections in Japan. Journal of Veterinary Medical Science 64, 325-328.
- JANSEN, B.C., 1953. The parasiticidal effect of aureomycin (Lederle) on Babesia equi (Laveran 1899) in splenectomised donkeys. Onderstepoort Journal of Veterinary Research, 26, 175–182.
- JOYNER, L.P., DONNELLY, J. & HUCK, R.A., 1981. Complement fixation tests equine piroplasmosis (Babesia equi and Babesia caballi) performed in the UK during 1976 to 1979. Equine Veterinary Journal, 13, 103–106.
- KAPPMEYER, L.S., PERRYMAN, L.E., HINES, S.A., BASZLER, T.V., KATZ, J.B., HENNAGER, S.G., KNOWLES, D.P., 1999. Detection of equine antibodies to babesia caballi by recombinant babesia caballi rhoptry-associated protein 1 in a competitive-inhibition enzyme-linked immunosorbent assay. Journal of Clinical Microbiology 37, 2285-2290.
- KAPPMEYER, L.S., THIAGARAJAN, M., HERNDON, D.R., RAMSAY, J.D., CALER, E., DJIKENG, A., GILLESPIE, J.J., LAU, A.O., ROALSON, E.H., SILVA, J.C., SILVA, M.G., SUAREZ, C.E., UETI, M.W., NENE, V.M., MEALEY, R.H., KNOWLES, D.P., BRAYTON, K.A., 2012. Comparative genomic analysis and phylogenetic position of Theileria equi. BMC Genomics 13, 603.
- KIM, C.M., BLANCO, L.B., ALHASSAN, A., ISEKI, H., YOKOYAMA, N., XUAN, X., IGARASHI, I., 2008. Diagnostic real-time PCR assay for the quantitative detection of Theileria equi from equine blood samples. Veterinary Parasitology, 151, 158-163.
- KIRKHAM, W.W., 1969. The treatment of equine babesiosis. Journal of the American Veterinary Medical Association, 155, 457–461.
- KLINCKMANN, G., 1981. Sporozoitenstabilate von Babesia equi aus Hyalomma anatolicum anatolicum und Rhipicephalus turanicus. Inaugural Dissertation aus dem Institut für Parasitologie der Tierärztlichen Hochschule Hannover, 6–47.
- KNOWLES, D., JR., 1996. Equine babesiosis (piroplasmosis): a problem in the international movement of horses. British veterinary journal 152, 123-126.
- KNOWLES, D.P. JR, KAPPMEYER, L.S., STILLER, D., HENNAGER, S.G. & PERRYMAN, L.E., 1992. Antibody to a recombinant merozoite protein epitope identifies horses infected with Babesia equi. Journal of Clinical Microbiology, 30, 3122–3126.
- KNOWLES, D.P. JR, PERRYMAN, L.E., KAPPMEYER, L.S. & HENNAGER, S.G., 1991. Detection of equine antibody to Babesia equi merozoite proteins by a monoclonal antibody-based competitive inhibition enzyme-linked immunosorbent assay. Journal of Clinical Microbiology, 29, 2056–2058.
- KNOWLES, D.P., JR., PERRYMAN, L.E., GOFF, W.L., MILLER, C.D., HARRINGTON, R.D., GORHAM, J.R., 1991. A monoclonal antibody defines a geographically conserved surface protein epitope of Babesia equi merozoites. Infection and Immunity 59, 2412-2417.
- KNOWLES, R.C. & UNISS-FLOYD, R., 1983. Equine piroplasmosis (Babesiosis) of the Babesia caballi type. Equine Practice, 5, 18–22.
- KOCH, R., 1904. Rhodesian investigations. Cape Agricultural Journal, 24, 33–45.
- KOCH, R., 1906. Beiträge zur Entwicklungsgeschichte der Piroplasmen. Zeitschrift für Hygiene und Infectionskrankheiten, 54, 1–9.
- KOUAM, M.K., KANTZOURA, V., MASUOKA, P.M., GAJADHAR, A.A., THEODOROPOULOS, G., 2010. Genetic diversity of equine piroplasms in Greece with a note on speciation within Theileria genotypes (Theileria equi and Theileria equi-like). Infection, Genetics and Evolution 10, 963-968.
- KUMAR, S., GUPTA, A.K., PAL, Y., DWIVEDI, S.K., 2003. In-vivo therapeutic efficacy trial with artemisinin derivative, buparvaquone and imidocarb dipropionate against Babesia equi infection in donkeys. Journal of Veterinary Medical Science 65, 1171-1177.
- KUTTLER, K.L., GIPSON, C.A., GOFF, W.L. & JOHNSON, L.W., 1986. Experimental Babesia equi infection in mature horses. American Journal of Veterinary Research, 47, 1668–1670.
- KUTTLER, K.L., ZAUGG, J.L. & GIPSON, C.A., 1987. Imidocarb and parvaquone in the treatment of piroplasmosis (Babesia equi) in equids. American Journal of Veterinary Research, 48, 1613–1616.
- LAVERAN, A., 1901. Contribution a’ l’etude du Piroplasma equi. Comptes rendus des seances. Societe de Biologie et de ses Filiales, 53, 385–388.
- LEVINE, N.D., 1985. Veterinary Protozoology. Ames: Iowa State University Press.
- LEWIS, B.D., 1998. Transplacental transmission of Babesia equi in horses and chemotherapy of small Babesia species. PhD thesis, Faculty of Veterinary Science, University of Pretoria, South Africa.
- LEWIS, B.D., PENZHORN, B.L., VOLKMANN, D.H., 1999. Could treatment of pregnant mares prevent abortions due to equine piroplasmosis? Journal of the South African Veterinary Association 70, 90-91.
- LEWIS, D.J., 1987. Hypophosphataemia: A feature of malaria. British Medical Journal, 295, 416–417.
- LEWIS, M.J., WAGNER, B., WOOF, J.M., 2008. The different effector function capabilities of the seven equine IgG subclasses have implications for vaccine strategies. Molecular Immunology, 45, 818-827.
- LIEBISCK, A. & RAHMAN, M.S., 1976. Zum Vorkommen und zur vektoriellen Bedeutung der Zecken Dermacentor marginatus (Sulzer, 1779) und Dermacentor reticulatus (Fabricius, 1794) im Deutschland. Tropenmedicine und Parasitology, 27, 393–404.
- LITTLEJOHN, A., 1963. Babesiosis. In: BONE, J.F., CATCOTT, E.J., GABEL, A.A., JOHNSON, L.E. & RILEY, W.F., (eds). Equine Medicine and Surgery. Santa Barbara, California: American Veterinary Publications.
- LITTLEJOHN, A., SCHLEGELMILCH, R.A. & LE ROUX, J.P., 1977. Patterns of equine disease in southern Africa in 1973. Veterinary Clinician, 25, 3–11 & 26, 15–20.
- LIU, Q., MELI, M.L., ZHANG, Y., MEILI, T., STIRN, M., RIOND, B., WEIBEL, B., HOFMANN-LEHMANN, R., 2016. Sequence heterogeneity in the 18S rRNA gene in Theileria equi from horses presented in Switzerland. Veterinary Parasitology 221, 24-29.
- MACGREITH, B.G., GILLES, H.M. & DEVANKUL, K., 1957. Pathological processes in Babesia canis infections. Tropenmedizin und Parasitologie, 8, 485–514.
- MACKENSTEDT, U., GAUER, M., FUCHS, P., ZAPF, F., SCHEIN, E. & MEHLHORN, H., 1995. DNA measurements reveal differences in the life cycles of Babesia bigemina and Babesia canis, two typical members of the genus Babesia. Parasitology Research, 81, 595–604.
- MADDEN, P.A. & HOLBROOK, A.A., 1968. Equine piroplasmosis: Indirect fluorescent antibody test for Babesia caballi. American Journal of Veterinary Research, 29, 117–123.
- MAHONEY, D.F. & SAAL, J.R., 1961. Bovine babesiosis: Thick blood films for the detection of parasitaemia. Australian Veterinary Journal, 37, 44–47.
- MAHONEY, D.F., WRIGHT, I.G., FRERICHS, W.M., GROENENDYK, S., O’SULLIVAN, D.M., ROBERTS, M.C. & WADDELL, A.H., 1977. Identification of Babesia equi in Australia. Australian Veterinary Journal, 53, 461–464.
- MARTIN, R., 1999. Equine piroplasmosis: the temporary importation of seropositive horses into Australia. Australian Veterinary Journal 77, 308-309.
- MEHLHORN, H. & SCHEIN, E., 1984. The piroplasms: Life cycle and sexual stages. In: MULLER, R. & BAKER, J.R., (eds). Advances in Parasitology. London: Academic Press, 23, 37–103.
- MEHLHORN, H. & SCHEIN, E., 1998. Redescription of Babesia equi Laveran, 1901 as Theileria equi. Mehlhorn, Schein 1998. Parasitology Research, 84, 467–475.
- MEHLHORN, H., SCHEIN, E. & VOIGT, W.P., 1980. Light and electron microscopic study on developmental stage of Babesia canis within the gut of the tick Dermacentor reticulatus. Journal of Parasitology, 66, 220–228.
- MERKLE, F.J., 1983. Untersuchungen über die Brauchbarkeit von KBR, IFAT und ELIZA zum nachweis der Babesia caballi Infektion des Pferdes. Inaugural Dissertation aus dem Institut für Vergleichende Tropenmedizin und Parasitologie der Tierärztlichen Fakultät der Universität München, 1–44.
- MEYER, C., GUTHRIE, A.J., STEVENS, K.B., 2005. Clinical and clinicopathological changes in 6 healthy ponies following intramuscular administration of multiple doses of imidocarb dipropionate. Journal of the South African Veterinary Association 76, 26-32.
- MEYWARD, J.A., 1951. Piroplasmose congénitale chez le Cheval. Recuel de Médecine Véterinaire, 127, 340–342.
- MOLTMANN, U.G., MEHLHORN, H., SCHEIN, E., REHBEIN, G., VOIGT, W.P. & SWEYGARTH, E., 1983. Fine structure of Babesia equi Leveran, 1901 within lymphocytes and erythrocytes of horses: An in vivo and in vitro study. Journal of Parasitology, 69, 111–120.
- MOLTMANN, U.G., MEHLHORN, H., SCHEIN, E., VOIGT, W.P. & FRIEDHOFF, K.T., 1983. Ultrastructural study on the development of Babesia equi (Coccidia: Piroplasmia) in the salivary glands of its vector ticks. Journal of Protozoology, 30, 218–225.
- MORZARIA, S.P., BROCKLESBY, D.W. & HARRADINE, D.L., 1977. Evaluation of the indirect fluorescent antibody test for Babesia major and Theileria mutans in Britain. The Veterinary Record, 100, 484–487.
- NEITZ, W.O., 1956. Classification, transmission and biology of piroplasms of domestic animals. Annals of the New York Academy of Science, 64, 56–111.
- NICOLAIEWSKY, T.B., RICHTER, M.F., LUNGE, V.R., CUNHA, C.W., DELAGOSTIN, O., IKUTA, N., FONSECA, A.S., DA SILVA, S.S., OZAKI, L.S., 2001. Detection of Babesia equi (Laveran, 1901) by nested polymerase chain reaction. Veterinary Parasitology 101, 9-21.
- NUNN, J.A., 1894. Specific fevers of malarial origin in equines. Veterinary Journal, 39, 402–405.
- NUTTALL, G.H.F. & STRICKLAND, C., 1910. Die Parasiten des Pferdepiroplasmose resp. der ‘Biliary fever’. Centralblatt für Bakteriologie, Parasitenkunde und Infektionskrankheiten Abteilung I, 56, 524–525.
- NUTTALL, G.H.F. & STRICKLAND, C., 1912. On the occurrence of two species of parasites in equine piroplasmosis or biliary fever. Parasitology, 5, 65–96.
- OGAWA, E., KOBAYASHI, K., HOSHIURA, N. & MUKAI, J., 1987. Bovine postparturient haemoglobinaemia: Hypophosphataemia and metabolic disorder in red blood cells. American Journal of Veterinary Research, 48, 1300–1303.
- OLIVIER, A., NURTON, J.P. & GUTHRIE, A.J., 1997. An epizoological study of wastage in thoroughbred racehorses in Gauteng, South Africa. Journal of the South African Veterinary Association, 68, 125–129.
- PANDIT, S.P. & SINGH, B., 1982. Babesia equi infection in Maharashtra: Prevalence and clinicopathological changes induced by splenectomization in donkeys. Indian Journal of Veterinary Medicine, 2, 68–69.
- PHIPPS, L.P., OTTER, A., 2004. Transplacental transmission of Theileria equi in two foals born and reared in the United Kingdom. Veterinary Record, 154, 406-408.
- POSNETT, E.S. & AMBROSIO, R.E., 1989. DNA probes for detection of Babesia equi. Molecular and Biochemical Parasitology, 34, 75–78.
- POSNETT, E.S., 1988. Veterinary Research Institute, Onderstepoort. Unpublished data.
- PURCHASE, H.S., 1974. Piroplasmosis in foal at birth. The Veterinary Record, 59, 449.
- PURNELL, R.E. & JOYNER, L.P., 1968. The development of Theileria parva in the salivary glands of the tick Rhipicephalus appendiculatus. Parasitology, 58, 725–732.
- QABLAN, M.A., OBORNIK, M., PETRZELKOVA, K.J., SLOBODA, M., SHUDIEFAT, M.F., HORIN, P., LUKES, J., MODRY, D., 2013. Infections by Babesia caballi and Theileria equi in Jordanian equids: epidemiology and genetic diversity. Parasitology 140, 1096-1103.
- QABLAN, M.A., SLOBODA, M., JIRKU, M., OBORNIK, M., DWAIRI, S., AMR, Z.S., HORIN, P., LUKES, J., MODRY, D., 2012. Quest for the piroplasms in camels: identification of Theileria equi and Babesia caballi in Jordanian dromedaries by PCR. Veterinary Parasitology 186, 456-460.
- RAMSAY, J.D., UETI, M.W., JOHNSON, W.C., SCOLES, G.A., KNOWLES, D.P., MEALEY, R.H., 2013. Lymphocytes and macrophages are infected by Theileria equi, but T cells and B cells are not required to establish infection in vivo. PLoS One 8, e76996.
- RAPOPORT, A., AHARONSON-RAZ, K., BERLIN, D., TAL, S., GOTTLIEB, Y., KLEMENT, E., STEINMAN, A., 2014. Molecular characterization of the Babesia caballi rap-1 gene and epidemiological survey in horses in Israel. Infection, Genetics and Evolution 23, 115-120.
- RASHID, H.B., CHAUDHRY, M., RASHID, H., PERVEZ, K., KHAN, M.A., MAHMOOD, A.K., 2008. Comparative efficacy of diminazene diaceturate and diminazene aceturate for the treatment of babesiosis in horses. Tropical Animal Health and Production 40, 463-467.
- RETIEF, G.P., 1964. A comparison of equine piroplasmosis in South Africa and the United States. Journal of the American Veterinary Medical Association, 145, 912–916.
- RHALEM, A., SAHIBI, H., LASRI, S., JOHNSON, W.C., KAPPMEYER, L.S., HAMIDOUCH, A., KNOWLES, D.P., GOFF, W.L., 2001. Validation of a competitive enzyme-linked immunosorbent assay for diagnosing Babesia equi infections of Moroccan origin and its use in determining the seroprevalence of Babesia equi in Morocco. Journal of Veterinary Diagnostic Investigation 13, 249-251.
- RISTIC, M., 1985. Equine babesiosis and trypanosomiasis. First International Symposium on Equine Haematology, Michigan, Michigan State University.
- ROBERTS, E.D., MOREHOUSE, L.J., GAINER, J.H. & MCDANIEL, H.A., 1962. Equine piroplasmosis. Journal of the American Veterinary Medical Association, 141, 1323–1329.
- ROTHSCHILD, C., KNOWLES, D., 2007. Equine piroplasmosis, In: SELLON, D.C., (ed.). Equine Infectious Diseases. Long Mt. Saunders, Elsevier, St. Louis, 465-473.
- RUDZINSKA, M.A. & TRAGER, W., 1977. Formation of merozoites in intra-erythrocytic Babesia microti: An ultrastructural study. Canadian Journal of Zoology, 55, 928–938.
- RUDZINSKA, M.A., SPIELMAN, A., RIEK, R.F., LEWENGRUB, S.J. & PIESMAN, I., 1979. Intra-erythrocytic ‘gametocytes’ of Babesia microti and their maturation in ticks. Canadian Journal of Zoology, 57, 424–434.
- SALABARRIA, F.F., GODSHEAV, A., FERRER, J., JIMINEZ, T., VILLALBA, G. & JORGE, J., 1981. Babesia (Nuttallia) equi y Babesia caballi en cebras (Equus zebra). Diagnostico morfologico y serologica. Revista Cubana de Ciencias Veterinarias, 2, 171–176.
- SALIM, B., BAKHEIT, M.A., KAMAU, J., NAKAMURA, I., SUGIMOTO, C., 2010. Nucleotide sequence heterogeneity in the small subunit ribosomal RNA gene within Theileria equi from horses in Sudan. Parasitology Research, 106, 493-498.
- SANT, C., D'ABADIE, R., PARGASS, I., BASU, A.K., ASGARALI, Z., CHARLES, R.A., GEORGES, K.C., 2016. Prospective study investigating transplacental transmission of equine piroplasmosis in thoroughbred foals in Trinidad. Veterinary Parasitology 226, 132-137.
- SCHEIN, E., REHBEIN, G., VOIGT, W.P. & ZWEYGARTH, E., 1981. Babesia equi (Leveran 1901). Development in horses and in lymphocyte culture. Tropenmedizin und Parasitologie, 32, 223–227.
- SCHEIN, L. & FRIEDHOFF, K.T., 1978. Lichtmikroskopische Untersuchungen über die Entwicklung von Theileria annulata (Dschunkowsky & Luhs, 1904) in Hyalomma anatolicum excavatum (Koch. 1844). Zeitschrift für Parasitenkunden, 56, 287–303.
- SCHWINT, O.N., UETI, M.W., PALMER, G.H., KAPPMEYER, L.S., HINES, M.T., CORDES, R.T., KNOWLES, D.P., SCOLES, G.A., 2009. Imidocarb dipropionate clears persistent Babesia caballi infection with elimination of transmission potential. Antimicrobial Agents and Chemotherapy 53, 4327-4332.
- SCOLES, G.A., HUTCHESON, H.J., SCHLATER, J.L., HENNAGER, S.G., PELZEL, A.M., KNOWLES, D.P., 2011. Equine piroplasmosis associated with Amblyomma cajennense Ticks, Texas, USA. Emerging Infectious Diseases 17, 1903-1905.
- SCOLES, G.A., UETI, M.W., 2013. Amblyomma cajennense is an intrastadial biological vector of Theileria equi. Parasites & Vectors 6, 306.
- SCOLES, G.A., UETI, M.W., 2015. Vector ecology of equine piroplasmosis. Annual Review of Entomology 60, 561-580.
- SHORT, M.A., CLARK, C.K., HARVEY, J.W., WENZLOW, N., HAWKINS, I.K., ALLRED, D.R., KNOWLES, D.P., CORN, J.L., GRAUSE, J.F., HENNAGER, S.G., KITCHEN, D.L., TRAUB-DARGATZ, J.L., 2012. Outbreak of equine piroplasmosis in Florida. Journal of the American Veterinary Medical Association 240, 588-595.
- SIGG, L., GERBER, V., GOTTSTEIN, B., DOHERR, M.G., FREY, C.F., 2010. Seroprevalence of Babesia caballi and Theileria equi in the Swiss horse population. Parasitology International 59, 313-317.
- SIMPSON, C.F., KIRKHAM, W.W. & KLING, J.M., 1967. Comparative morphologic features of Babesia caballi and Babesia equi. American Journal of Veterinary Science, 28, 1693–1697.
- SLOBODA, M., JIRKU, M., LUKESOVA, D., QABLAN, M., BATSUKH, Z., FIALA, I., HORIN, P., MODRY, D., LUKES, J., 2011. A survey for piroplasmids in horses and Bactrian camels in North-Eastern Mongolia. Veterinary Parasitology 179, 246-249.
- TAYLOR, W.M., 1972. Chemotherapy of equine piroplasmosis. Proceedings of the Third International Conference on Equine Infectious Diseases, Paris: S. Krager, Basel.
- TAYLOR, W.M., BRYANT, J.E., ANDERSON, J.B. & WILLERS, K.M.A., 1969. Equine piroplasmosis in the United States—a review. Journal of the American Veterinary Medical Association, 155, 915–919.
- TENTER, A.M. & FRIEDHOFF, K.T., 1986. Serodiagnosis of experimental and natural Babesia equi and Babesia caballi infections. Veterinary Parasitology, 20, 49–61.
- TENTER, A.M., OTTE, M.J., GONZALEZ, C.A., ABUABARA, Y., 1988. Prevalence of piroplasmosis in equines in the Colombian province of Cordoba. Tropical Animal Health and Production 20, 93-98.
- THEILER, A., 1901. Die Pferde-Malaria. Schweizer Archiv für Tierheilkunde, 43, 253–280.
- THEILER, A., 1902. Equine malaria. Journal of Comparative Pathology and Therapeutics, 15, 40–45.
- THEILER, A., 1905. Further notes on piroplasmosis of the horse, mule and donkey. Journal of Comparative Pathology and Therapeutics, 18, 229–239.
- THEILER, A., 1906. Transmission of equine piroplasmosis by ticks in South Africa. Journal of Comparative Pathology and Therapeutics, 19, 283–292.
- THEILER, G., 1950. Zoological survey of the Union of South Africa. Tick survey, part V. Distribution of Rhipicephalus evertsi, the red tick. Onderstepoort Journal of Veterinary Science and Animal Industry, 24, 33–36.
- THEILER, G., 1956. Zoological survey of the Union of South Africa. Tick survey—part IX. The distribution of the three South African Hyalommas or bontpoots. Onderstepoort Journal of Veterinary Research, 27, 239–269.
- UETI, M.W., MEALEY, R.H., KAPPMEYER, L.S., WHITE, S.N., KUMPULA-MCWHIRTER, N., PELZEL, A.M., GRAUSE, J.F., BUNN, T.O., SCHWARTZ, A., TRAUB-DARGATZ, J.L., HENDRICKSON, A., ESPY, B., GUTHRIE, A.J., FOWLER, W.K., KNOWLES, D.P., 2012. Re-emergence of the apicomplexan Theileria equi in the United States: elimination of persistent infection and transmission risk. PLoS One 7, e44713.
- UETI, M.W., PALMER, G.H., KAPPMEYER, L.S., SCOLES, G.A., KNOWLES, D.P., 2003. Expression of equi merozoite antigen 2 during development of Babesia equi in the midgut and salivary gland of the vector tick Boophilus microplus. Journal of Clinical Microbiology 41, 5803-5809.
- UETI, M.W., PALMER, G.H., SCOLES, G.A., KAPPMEYER, L.S., KNOWLES, D.P., 2008. Persistently infected horses are reservoirs for intrastadial tick-borne transmission of the apicomplexan parasite Babesia equi. Infectious and Immunity, 76, 3525-3529.
- VAN AMSTEL, S.R., OLIVIER, G.C. & REYERS, F., 1987. Gedissemineerde intravaskulêre stolling in perde: ’n Verslag van ses gevalle. Journal of the South African Veterinary Association, 58, 109–112.
- VAN HEERDEN, J., 1987–1998. Medical University of Southern Africa, 1996–1998. Private Veterinary Practice, 16 Dalham Road, Kimberley, South Africa. Unpublished observations.
- VAN HEERDEN, J., 1996 Equine babesiosis in South Africa: a report of two cases. Equine Veterinary Education, 8, 3–5.
- WANG, M., GUO, W., IGARASHI, I., XUAN, X., WANG, X., XIANG, W., JIA, H., 2014. Epidemiological investigation of equine piroplasmosis in China by enzyme-linked immunosorbent assays. Journal of Veterinary Medical Science 76, 549-552.
- WARNER, A. & MORRIS, D.D., 1987. Haemolytic anaemias. In: ROBINSON, N.E., (ed.). Current Therapy in Equine Medicine. Philadelphia: W.B. SAUNDERS Company.
- WEBER, G. & FRIEDHOFF, K.T., 1977. Preliminary observations on the ultrastructure of supposed sexual stages of Babesia bigemina (Piroplasmae). Zeitschrift für Parasitenkunde, 53, 83–92.
- WEILAND, G., 1986. Species-specific serodiagnosis of equine piroplasma infections by means of complement fixation test (CFT) immunofluorescence (IFA) and enzyme-linked immunosorbent assay (ELISA). Veterinary Parasitology, 20, 43–48.
- WENYON, C.M., 1926. Protozoology, a Manual for Medical Men, Veterinarians and Zoologists. London: Bailliére Tindal & Co, 2.
- WISE, L.N., KAPPMEYER, L.S., MEALEY, R.H., KNOWLES, D.P., 2013. Review of equine piroplasmosis. Journal of Veterinary Internal Medicine 27, 1334-1346.
- WISE, L.N., PELZEL-MCCLUSKEY, A.M., MEALEY, R.H., KNOWLES, D.P., 2014. Equine piroplasmosis. Veterinary Clinics of North America. Equine Practice 30, 677-693.
- XUAN, X., CHAHAN, B., HUANG, X., YOKOYAMA, N., MAKALA, L.H., IGARASHI, I., FUJISAKI, K., MARUYAMA, S., SAKAI, T., MIKAMI, T., 2002. Diagnosis of equine piroplasmosis in Xinjiang province of China by the enzyme-linked immunosorbent assays using recombinant antigens. Veterinary Parasitology 108, 179-182.
- YOUNG, A.S. & PURNELL, R.E., 1973. Observations on Babesia equi in the salivary glands of Rhipicephalus evertsi. Bulletin of Epizootic Diseases of Africa, 21, 377–383.
- ZAUGG, J.L. & LANE, V.M., 1992. Efficacy of buparvaquone as a therapeutic and clearing agent of Babesia equi of European origin in horses. American Journal of Veterinary Research, 53, 1396–1399.
- ZWEYGARTH, E., JUST, M.C. & DE WAAL, D.T., 1995. Continuous in vitro cultivation of erythrocytic stages of Babesia equi. Parasitology Research, 81, 355–358.
- ZWEYGARTH, E., JUST, M.C. & DE WAAL, D.T., 1997. In vitro cultivation of Babesia equi: detection of carrier animals and isolation of parasites. Onderstepoort Journal of Veterinary Research, 64, 51–56.